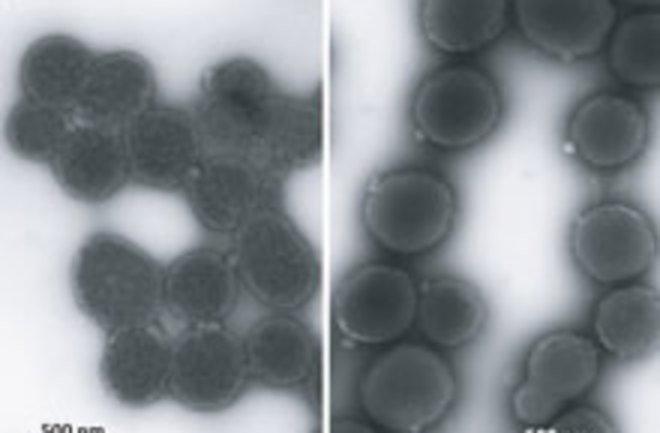
discover magazine

craig venter artificial life
He explains how they did it and why the achievement marks the beginning of a new era for science. Artificial life made in lab can grow and divide like natural bacteria. Craig venter institute jcvi the national institute of standards and technology nist and.
Craig venter institute 10355 science center drive san diego ca 92121 usa.

Craig venter artificial life. In 2010 a 1079 kb genome based on the genome of mycoplasma mycoides jcv syn1 0 was chemically synthesized and supported cell growth when transplanted into cytoplasm. A goal in biology is to understand the molecular and biological function of every gene in a cell. Craig venter institute 9704 medical center drive rockville md 20850 usa. Advances in synthetic biology genome transplant.
Craig venter research institute jcvi in the united states took synthetic biology to a new level when they successfully transplanted the entire genome of one species of bacterium mycoplasma mycoides into the cytoplasm of another mycoplasma capricolum accomplishing the first full genome transplant. The ability to routinely write the software of life will usher in a new era in science and with it new products and applications such as advanced biofuels clean water technology and new vaccines and medicines. Yet another synthetic life claim. To whom correspondence should be addressed.
They ve created the first fully functioning reproducing cell controlled by synthetic dna. He is known for leading the first draft sequence of the human genome and assembled the first team to transfect a cell with a synthetic chromosome. 15 april 2021 gmt 10 headlines are again buzzing about an apparent creation of a perfectly self replicating synthetic cell 1 this came from a collaboration between the j. Craig venter institute jcvi where he currently serves as ceo.
Venter founded celera genomics the institute for genomic research tigr and the j. In 2010 scientists at the j. Craig venter and team make a historic announcement. The field is already having an impact in some of these areas and will continue to do so.
The single celled organism based on an existing bacterium that causes mastitis in goats but at its core is an entirely synthetic genome that was constructed from three chemicals in the laboratory. Craig venter institute jcvi announced the world s first synthetic life form. It is a branch of science that encompasses a broad range of methodologies from various disciplines such as biotechnology genetic engineering molecular biology molecular engineering systems biology. One way to approach this is to build a minimal genome that includes only the genes essential for life.
In june 2007 scientists at the j. In 2016 researchers led by craig venter at the j. Synthetic biology synbio is a multidisciplinary area of research that seeks to create new biological parts devices and systems or to redesign systems that are already found in nature. What should we make of the new syn3a cells.
venter s research team creates an artificial cell and reports that 32 of genes are life essential but contain unknown functions dark daily